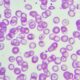
¿Qué son las talasemias?

La inflamación idiopática de la órbita, a menudo conocida como seudotumor inflamatorio orbitario, es una enfermedad inflamatoria que afecta los tejidos de la órbita ocular. Esta afección puede presentarse de diversas maneras, incluyendo la inflamación de todos los tejidos orbitarios, limitarse a estructuras específicas como la glándula lagrimal, los músculos extraoculares o la cápsula de Tenon.
Inflamación de Todos los Tejidos Orbitarios
Cuando la inflamación idiopática de la órbita afecta a todos los tejidos orbitarios, se caracteriza por una inflamación generalizada y difusa en la órbita ocular. Esto puede involucrar una respuesta inmunitaria anormal en el tejido graso, los músculos orbitarios, la glándula lagrimal y otras estructuras orbitarias. Los síntomas pueden incluir proptosis (desplazamiento del ojo hacia adelante), dolor ocular, visión borrosa y enrojecimiento. Esta forma de la enfermedad puede ser unilateral o bilateral, lo que significa que puede afectar un solo ojo o ambos.
Dacrioadenitis Esclerosante (Afectación de la Glándula Lagrimal)
En algunos casos, la inflamación idiopática de la órbita se limita específicamente a la glándula lagrimal, lo que se conoce como dacrioadenitis esclerosante. La glándula lagrimal es responsable de producir lágrimas, y su inflamación puede causar dolor en la región de la glándula lagrimal y molestias oculares. Esta forma de la enfermedad también puede ser unilateral o bilateral.
Miositis Orbitaria (Afectación de los Músculos Extraoculares)
Cuando la inflamación se concentra en los músculos extraoculares, se denomina miositis orbitaria. Los músculos extraoculares son responsables de los movimientos oculares. La inflamación de estos músculos puede causar dolor ocular, limitación en los movimientos del ojo y cambios en la alineación ocular, lo que puede llevar a la diplopía (visión doble). Al igual que las otras formas de la enfermedad, la miositis orbitaria puede afectar uno o ambos ojos.
Escleritis Posterior (Afectación de la Cápsula de Tenon)
La cápsula de Tenon es una membrana de tejido conectivo que envuelve el ojo y se encuentra en la parte posterior de la órbita. Cuando esta estructura se inflama, se conoce como escleritis posterior. Esta forma de inflamación idiopática de la órbita puede causar dolor detrás del ojo, sensibilidad a la presión y cambios en la posición del ojo.
La causa exacta de la inflamación idiopática de la órbita no se comprende por completo, pero se cree que está relacionada con una respuesta inmunitaria anormal. Se piensa que el sistema inmunológico ataca de manera incorrecta los tejidos orbitarios, desencadenando una inflamación crónica. La inflamación crónica puede llevar a la fibrosis y cicatrización de los tejidos, lo que contribuye a los síntomas observados en esta enfermedad.
Síguenos en X: @el_homomedicus y @enarm_intensivo Síguenos en instagram: homomedicus y en Treads.net como: Homomedicus